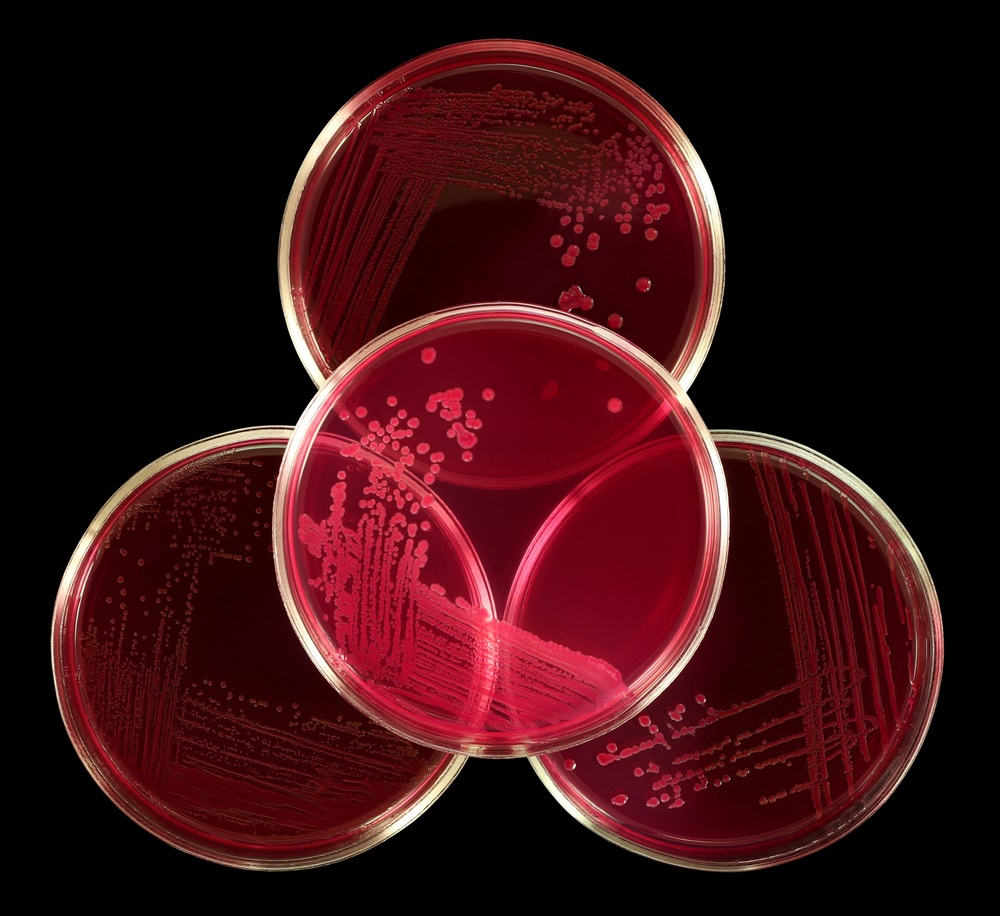

Management of GC for Providers
Flow Diagram of Clinician Encounter and Decision-Making
Each box is a link to the relevant section on this page.
Collect a Sexual Health History
Collecting a sexual history is critical to elicit symptoms of STIs, identify individuals at elevated risk of STIs, as well as to guide specific testing practices (e.g. pharyngeal and rectal swabs).
There are numerous resources to assist patients in collecting a sexual history, including CDC’s “Taking A Sexual History.”
- It is important to avoid assumptions about patients’ or patients’ partners’ sexual orientation, gender, or gender identity.
- Health care providers should not assume that a patient is at risk on the basis of gender identity; rather, risk assessment should be based on each individual’s sexual history
The National Coalition for Sexual Health’s toolkit provides additional resources for providing inclusive care:
- 6 Ps—partners, practices, past history of STIs, protection, pregnancy, and plus.
- The 6th P—plus—was created by the National Coalition for Sexual Health to address pleasure, problems, and pride.
Most women with gonorrhea do not have any symptoms. Even when a woman has symptoms, they are often mild and can be mistaken for a bladder or vaginal infection. Symptoms in women can include:
- Painful or burning sensation when peeing
- Increased vaginal discharge
- Vaginal bleeding between periods
- Abdominal pain
Men who have symptoms may have:
- A burning sensation when peeing
- A white, yellow, or green discharge from the penis
- Painful or swollen testicles (although this is less common)
Rectal infections may either cause no symptoms or cause symptoms in both men and women that may include:
- Discharge
- Anal itching
- Soreness
- Bleeding
- Painful bowel movements
Symptoms of a pharyngeal infection can include:
- Painful swelling of the lymph nodes
- A burning feeling in the throat
- Sore or dry throat, which might feel similar to having a cold

The CDC provides a comprehensive list of STI screening recommendations by disease and population of interest.
In addition to symptomatic individuals, regular screening testing is recommended for STIs for a range of populations:
Below is a brief overview of STD testing recommendations for gonorrhea.
- All sexually active women younger than 25 years should be tested for gonorrhea and chlamydia every year. Women 25 years and older with risk factors such as new or multiple sex partners or a sex partner who has an STI should also be tested for gonorrhea and chlamydia every year.
- All sexually active gay, bisexual, and other men who have sex with men should be tested at least once a year for syphilis, chlamydia, and gonorrhea. Those who have multiple or anonymous partners should be tested more frequently (e.g., every 3 to 6 months).
- People who have had oral or anal sex should talk with their healthcare provider about throat and rectal testing options.
Gonorrhea can be cured with the right treatment. CDC recommends a single dose of 500 mg of intramuscular ceftriaxone*. Alternative regimens are available when ceftriaxone cannot be used to treat urogenital or rectal gonorrhea.
*For persons weighing ≥150 kg, 1 g ceftriaxone should be administered. Doses and regimens vary for children and neonates.

Management of Gonorrhea for Sex Partners
Partners may be treated with a single dose of 800mg of oral cefixime. Seven days of 100mg doxycycline twice a day may be added if chlamydia is suspected.
Current Treatment Guidelines Video
Be alert for individuals who have persistent symptoms despite CDC-recommended treatment.
Any person with pharyngeal gonorrhea should return 7–14 days after initial treatment for a test of cure by using either culture or NAAT; however, testing at 7 days might result in an increased likelihood of false-positive tests.
If the NAAT is positive, efforts should be made to perform a confirmatory culture before retreatment, especially if a culture was not already collected. All positive cultures for test of cure should undergo antimicrobial susceptibility testing. Culture may be collected at the same time as NAAT.
Men or women who have been treated for gonorrhea should be retested 3 months after treatment regardless of whether they believe their sex partners were treated; scheduling the follow-up visit at the time of treatment is encouraged. If retesting at 3 months is not possible, clinicians should retest whenever persons next seek medical care <12 months after initial treatment.
If your practice needs supplies for clinical testing (such as BBL swabs) you can order them through the “Public Health Supply Testing Order Form” on the CDPHE website.
Samples can be shipped to the lab via the courier service.
Report a suspected Gonorrhea Treatment Failure
If a client's test of cure is positive, you must report a suspected treatment failure to the Colorado Department of Public Health and Environment.
They can be reached at:
CT/GC Surveillance………………...303-692-2697
DIS Pager Line………………………303-692-6996
Or by email: cdphe_sti_hiv_vhep_diseasereporting@state.co.us
Or through the reportal: http://reportal.colorado.gov
If you suspect your patient may have a treatment failure and your clinic or agency cannot perform a gonorrhea culture and susceptibility testing, our CO SURRG team can help coordinate culture testing and any necessary treatment through our partner site, the Denver Sexual Health Clinic. If the client is unable to commute to this clinic, culture testing supplies and susceptibility testing can be coordinated by the CO SURRG Team.
Dr. Karen Wendel is the Director of HIV/STD Prevention and Control Division at the Public Health Institute at Denver Health. In this capacity, she works with the Denver Sexual Health Clinic (DSHC) and Denver Prevention Training Center (DPTC) to promote STD education and care in our region and is the Medical Director for the CO SURRG Project. Through the DPTC, Dr. Wendel and her team can provide clinical consultation if you suspect GC treatment failure in a client. Consultation can be accessed through the STD Clinical Consultation Network (STDCCN).
